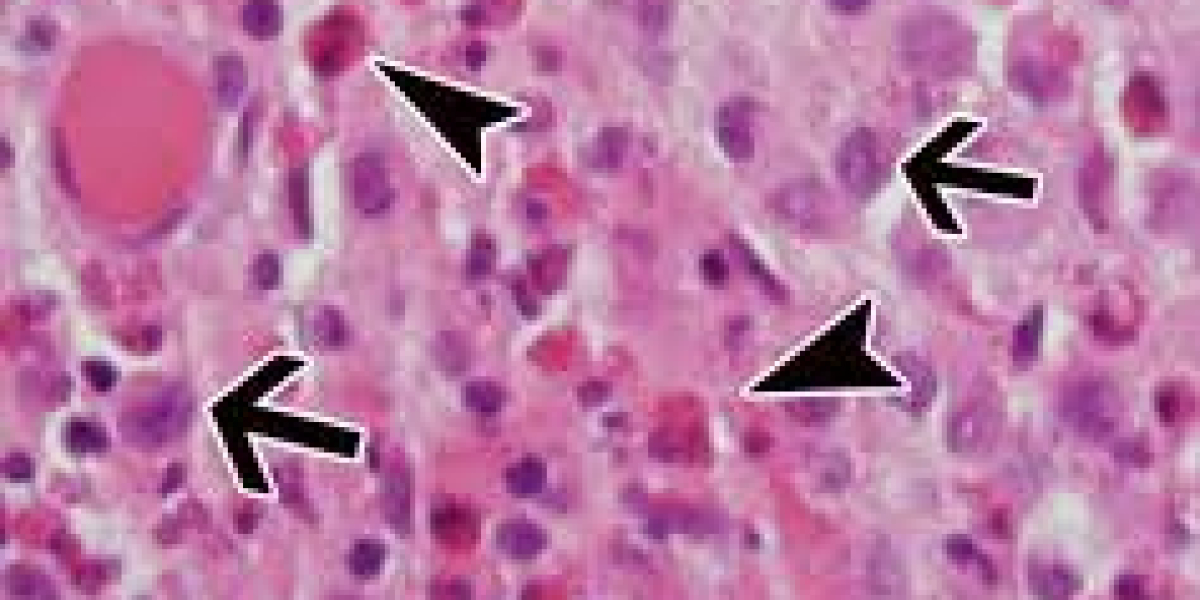
Langerhans Cell Histiocytosis Market Size, Epidemiology, Analysis & Trends 2023-2033

➾ Product Name - Hellomood CBD Gummies
➾ Main Benefits - Relief Stress, Pain Improve Health
➾ Category - Pain Relief
➾ Dosage - 2 Gummies per day
➾ Price - Online Check
➾ Result - 2-3Months
➾ Official Website - Click Here
✅Visit The Official Website To Get Your Bottle Now✅
✅Visit The Official Website To Get Your Bottle Now✅
✅Visit The Official Website To Get Your Bottle Now✅
Hellomood CBD Gummies Reviews: CBD gummies are becoming increasingly popular amongst adults looking for health and wellness benefits, including improved sleep, reduced stress, and relief from chronic pain. In fact, according to recent industry data, the global CBD gummies market is projected to reach $22.9 billion by 2026, rising at a compound annual growth rate of 29.5%.
For those looking to maximize the potential health benefits of CBD-infused gummies, Hellomood CBD Gummies are a fantastic option. Hellomood CBD Gummies are made using the finest quality, organic hemp extracted from 100% organic industrial hemp. The CBD used in the gummies is laboratory tested and certified so that you know you are getting a pure, high-quality product. The natural flavors and colors found in the gummies are derived from fruits, vegetables and botanicals, ensuring you’re only consuming good, natural ingredients.
To help you in knowing more about these gummies, here we are. We are discussing about Hellomood CBD Gummies from the Official Website in detail so that you can take these gummies right away!
Understanding what the Hellomood CBD Gummies are:
Hellomood CBD Gummies are a type of CBD-infused edible snack that provides a convenient way of consuming cannabidiol (CBD). CBD is a cannabinoid found in the cannabis plant that provides a range of health benefits for users. Hellomood CBD Gummies, offers a discreet, convenient way for users to enjoy CBD in addition to other health benefits. Each CBD gummy is infused with a precise amount of CBD that is designed to be taken orally.
CBD gummies are a great way to introduce CBD into ones' lifestyle without having to smoke, vape, or take an oil or tincture. Unlike some other methods for using CBD, you don’t have to measure or calculate the dosage or worry about any burning or intense effects. It is easy to consume, convenient, and offers consistent effects that can be felt within 30 to 45 minutes. It also helps to avoid any kind of side-effects that may be associated with inhalation of marijuana.
In addition to being a convenient way to get your daily dose of CBD, Hellomood CBD Gummies also provide a range of benefits like relief of anxiety, relief from chronic pain, improved focus and alertness, and improved sleep. For example, one of the key benefits of taking Hellomood CBD Gummies is that they are shown to reduce mood disturbances and improve sleep quality. CBD's ability to reduce stress and anxiety has been supported by scientific studies, and these effects may be even stronger when CBD is consumed as a gummy. Additionally, the anti-inflammatory properties of CBD can help in addressing pain, swelling, and other discomfort in the body.
Most of the CBD gummies on the market today are created with all-natural and organic ingredients that don’t contain any chemicals or artificial flavors. They provide an easy and convenient way to get your daily dose of CBD in a tasty treat.
Visit the Official Website of Hellomood CBD Gummies
Benefits of taking Hellomood CBD Gummies:
Several benefits that are a must to know are:
l Improved Mental Health:
Taking Hellomood CBD Gummies can help to reduce stress and anxiety, promoting a clear and calm state of mind. This can improve overall mental health and wellbeing.
l Reduced Chronic Pain:
CBD gummies can be an effective way to reduce chronic pain and inflammation associated with various illnesses and conditions. CBD has been scientifically proven to interact with endocannabinoids which can control and modulate inflammation, reducing pain.
l Improved Sleep:
CBD gummies can help to reduce stress levels which can improve sleep quality. Anxiety and stress can disrupt sleep, causing difficulty in falling asleep or staying asleep. CBD can help the body relax and reduce the levels of cortisol, a stress hormone which can disrupt sleep patterns.
l Improved Focus:
CBD has been shown to increase the amount of the neurotransmitter, acetylcholine, which is linked to improved focus and attention. Consumers of CBD gummies often report improved mental alertness, focus, and clarity.
l Optimal Balance:
Taking Hellomood CBD Gummies can help to maintain overall body balance, allowing the body and mind to operate at their optimal performance levels.
Order Hellomood CBD Gummies from the Official Website Only
How the Hellomood CBD Gummies promote weight loss: Science to know!
CBD gummies, which are derived from the hemp plant, have become popular as a natural way to promote weight loss. CBD has been studied for its potential ability to help reduce the appetite, facilitate fat burning, and increase energy levels. This has been shown to help people reach a healthier body weight.
CBD works by interacting with the endocannabinoid system, a network of neurotransmitters that helps regulate important bodily functions, including mood, pain, and energy levels. When CBD enters the system, it triggers the production of neurotransmitters that can help assuage hunger, reduce cravings, and reduce caloric intake, thus assisting in weight loss.
In addition to the potential appetite-regulating benefits of CBD, the supplement can also help you manage stress levels. Stress is a key factor in weight gain, as it can cause you to feel constantly hungry or can cause irrational or emotional eating habits. When you take CBD, it can help mitigate feelings of stress, allowing you to better manage your eating habits.
Lastly, CBD can provide additional benefits in terms of overall health. Many people make unhealthy eating choices in an attempt to lose weight, often leading to vitamin and mineral deficiencies. CBD gummies can help provide the nutrients that are needed for healthy weight loss. Taking CBD gummies along with an overall healthy lifestyle can help you lose weight more efficiently and effectively with fewer unhealthy cravings.
Order Hellomood CBD Gummies form the Official Website Only
FAQ:
l What are the health benefits of consuming Hellomood CBD Gummies?
Hellomood CBD Gummies can help improve overall health and wellness by promoting feelings of relaxation, reducing inflammation and aiding in sleep.
l Are Hellomood CBD Gummies safe to consume?
Yes, Hellomood CBD Gummies are made from high-quality, third-party tested ingredients and are completely safe for consumption.
l Is it easy to take Hellomood CBD Gummies?
Yes, taking Hellomood CBD Gummies is simple. Each gummy contains a pre-measured, precise dose of CBD, so you can get the exact amount of beneficial CBD with each serving. Hellomood CBD Gummies for Tinnitus may also work well.
l How do Hellomood CBD Gummies taste?
Hellomood CBD Gummies come in a delicious flavor so there is no need for you to worry about the taste at all!
l Are Hellomood CBD Gummies vegan-friendly?
Yes, Hellomood CBD Gummies are vegan-friendly. They are made with natural, plant-based ingredients with no animal products added. Hellomood CBD Gummies for Typr-2 Diabetes may also work well.
Hellomood CBD Gummies Price:
The CBD Gummies are available on very discounted prices. Check the price list below:
Buy 3 Get 2 Free - $39.98/bottle
Buy 2 Get 1 Free - $56.63/bottle
Buy 1 Get 1 Free - $64.94/bottle
* free shipping on all orders
Where to Buy Hellomood CBD Gummies?
This amazing CBD gummies are available for sale on the Official website of Hellomood CBD Gummies.
Order Hellomood CBD Gummies form the Official Website Only
Conclusion:
After understanding what Hellomood CBD Gummies are, it can be concluded that these gummies offer a convenient way to reap the therapeutic benefits of CBD without having to take any additional dietary supplements. CBD gummies are easy to use and provide a tasty, enjoyable experience. They also provide accurate, consistent doses of CBD, which can help to reduce stress, anxiety, inflammation and pain, as well as support a better, more productive sleep and an overall improvement in well-being.
Furthermore, CBD gummies are vegan-friendly, gluten-free and contain no THC, making them a natural, safe option for everyone. Hence, Hellomood CBD Gummies are a great choice for anyone looking to reap the benefits of CBD without compromising their health and lifestyle in any way.
Affiliate Disclosure Disclaimer: This is promotional content. Must consult your physician before taking pills. It is not approved by FDA. This post contains an affiliate link and we receive a commission on every sale from this post (at no cost to you).
RELATED TAGS:-
#HellomoodCBDGummiesSideEffects
#HellomoodCBDGummiesIngredients
#HellomoodCBDGummiesWhereToBuy
#HellomoodCBDGummiesOfficialWebsite
#HellomoodCBDGummiesHowToOrder
Order Hellomood CBD Gummies form the Official Website Only
https://www.facebook.com/hellomoodcbdgummies/
https://cbdtimes.blogspot.com/2023/04/hellomood-cbd-gummies.html
https://groups.google.com/g/hellomood-cbd-gummies-website/c/7miVbY7YzN0
https://hellomood-cbd-gummiesusa-1.jimdosite.com/
https://hellomood-cbd-gummiesus.company.site/
https://sites.google.com/view/hellomood-cbd-gummiesus/home
https://www.sympla.com.br/produtor/httpswwwfacebookcomhellomoodcbdgummies
https://hellomoodcbdu.cgsociety.org/bxqv/hellomood-cbd-gummie
https://hellomoodcbdu.cgsociety.org/g5uy/hellomood-cbd-gummie
https://in.pinterest.com/pin/1084241679018787856/
https://in.pinterest.com/pin/1084241679018787879/
https://www.tumblr.com/hellomoodcbdgummiesus
https://www.tumblr.com/hellomoodcbdgummiesus
https://xiaoxq.net/d/216194-hellomood-cbd-gummies-reviews-scam-or-legit-does-it-really-work
https://xiaoxq.net/d/216196-hellomood-cbd-gummies-reviews-price-where-to-buy
https://lookerstudio.google.com/reporting/b713aa7e-7d78-4905-b091-4c8c7d7386a9